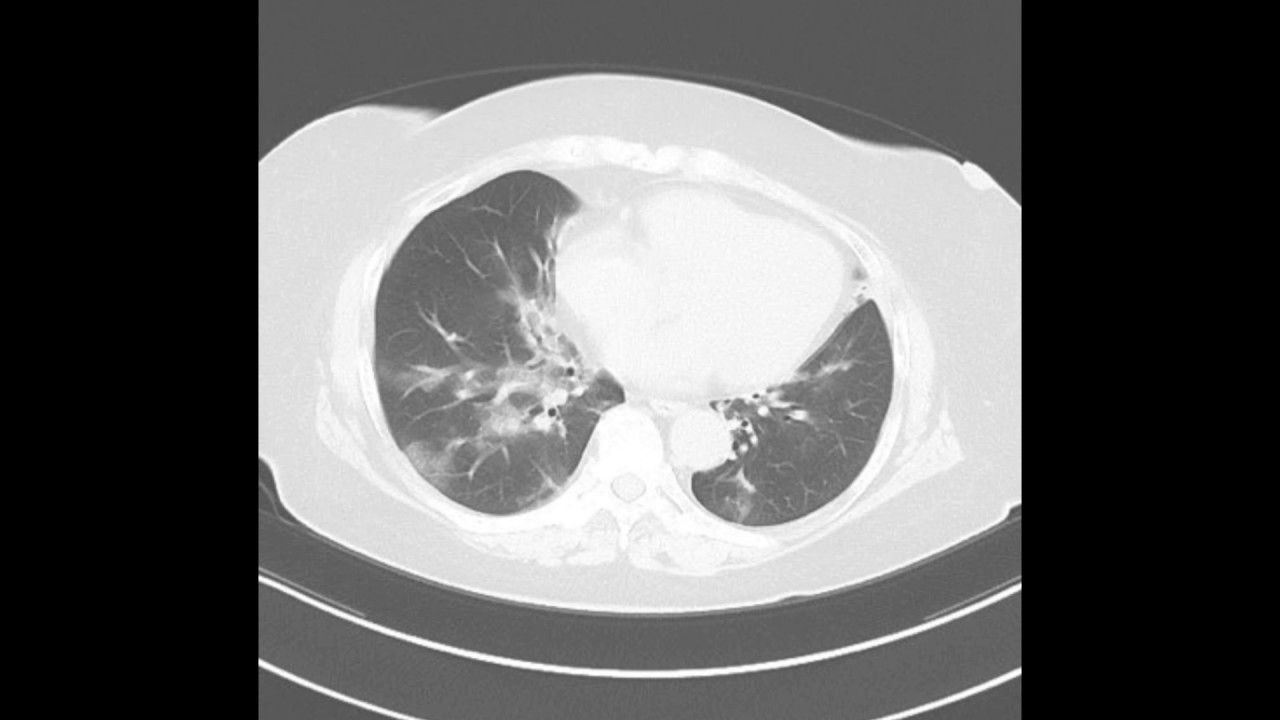
Ct画像あり ウイルス性肺炎まとめ 種類から症状 診断 治療まで

サイト メガロ 肺炎 お産や、母乳を授乳するときに、母親からもらうなどして、おとなの90%以上は、サイトメガロウイルスをもっています。 サイト メガロ ウイルス 感染。間質性肺炎がこれによるものと考えられる。エイズ患者では,その約30~40%にhcmv網膜 炎や脳炎が起こり,無治療だと失明または死亡に至る事もある。 5.臓器移植とhcmv感染症 移植患者にhcmv感染症が起こると(レシピエントの40~80%にhcmv感染症がおこるとPc肺炎は,最近では副腎皮質ホルモン剤(以下ステ ロイド剤)や免疫抑制剤を使用する膠原病患者にもし ばしばみられる日和見感染症の一つである1).サイト メガロウイルス肺炎(以下CMV肺炎)はニューモシス チス・カリニ肺炎(以下Pc肺炎)よりさらに

Ai E Learningシステム B版
サイト メガロ 肺炎
サイト メガロ 肺炎-サイトメガロウイルス性肺炎とはどんな病気か サイト メガロウイルス(CMV)はヘルペスウイルス属に属し、日本人成人の80~90%はすでに 幼少時から思春期にかけて感染し、ほとんどの人が不顕性(ふけんせい) gooヘルスケアサイトメガロウイルス(CMV)感染症 サイトメガロウイルス感染症はよくみられるヘルペスウイルス感染症で、症状が出ないものから、発熱と疲労感が出るもの(伝染性単核球症に似たもの)、また、眼や脳、その他の内臓を侵す重い症状が生じるものまで、症状は多様です。 この ウイルス は、体の分泌物と接触(性的接触とそれ以外の接触の両方)することで感染



免疫抑制状態のときに注意するべき呼吸器感染症 サイトメガロウイルス肺炎 臨床雑誌内科 104巻5号 医書 Jp
胸部単純X 線撮影では捉えられないCMV 間質性肺炎 の初期像を最も鋭敏に捉える9)(図2)推奨グレー ドB。 初感染例ではCMVAg が陽性化した時点,CMV disease 症状が発現(発熱)した時点で胸部CT を行うこ とが望ましい。初感染・既感染を問わず呼吸器症状が不全患者に発症した重症ニューモシスチス肺炎・サイト メガロウイルス肺炎にhfnc を使用することで,挿管人 工呼吸管理を回避出来た患者を報告している₁₀).上記の ように,加湿機能に優れ気道繊毛のクリアランス機能を見(血液培養からのクリプトコックスの検出,サイト メガロウイルス血中抗原検査における陽性細胞数の増 加)を基に判断すると,Cushing症候群による免疫不 全下での肺クリプトコックス症 クリプトコックス血 症とサイトメガロウイルス感染症を併発した
陽性,ウイルス量は300万コピー/˚lであった.サイト メガロウイルス・アンチゲネミア4/10と陽性,血清 画像診断 多発する嚢胞性,結節性陰影を呈したaids患者のニューモシスチス肺炎 渡辺 理沙 岩見 枝里 池村辰之介サイト メガロ ウイルス 髄 膜 症状 肺炎球菌性髄膜炎,肺炎,感染性心内膜炎 肺炎球菌性肺炎 髄膜炎 心内膜炎 »» もっと見る »» 同様の症状Published 11年6月21日 (IDWR 03年第15号) ヒトサイトメガロウイルス(以下CMV)感染症は、CMVの初感染、再感染あるいは再活性化によって起こる病態で、感染と感染症は異なることを明 確にする必要がある。 通常、幼小児期に不顕性感染の形で感染し、生涯その宿主に潜伏感染し、免疫抑制状態下で再活性化し、種々の病態を引き起こす。 このウ イルスが感染症を
日本脳炎、結核、インフルエンザ菌b 型、7 価肺炎球菌、ヒトパピローマウイルス に対するワクチンが、任意接種として、水痘、ムンプス、インフルエンザ、ロタウ イルス、A 型肝炎、B 型肝炎に対するワクチンがされている。メデカル社にCMV抗原血症の検索を外注していた (抗CMVpp65抗体,Biotest社,clonesC10andC11 を用い間接法で検索,5×104個の有核細胞中のpp65 陽性細胞を算定する).76件について同一材料を用い て我々の結果とシオノギバイオメデカル社に外注した成人女性の70%既にサイトメガロウイルスに感染したことがあり血液の中に 抗体(免疫)を持っていますが30%は感染を防ぐための抗体を持っていません 抗体を持っている方でもサイトメガロウイルスに感染することがありますが、抗体を 持っていない方は、サイトメガロウイルスの感染を受けやすいので、特に注意が必 要す。 妊娠中の感染以外に、分娩時・授乳



Ai E Learningシステム B版



学術論文 新型コロナウイルス間質性肺炎の本態は免疫介在性炎症性疾患である 高橋公太 日本医事新報社 Note出張版 Note
そこで、私たちは、尿サイト メガロウイルスdna が陽性で先天性サイト メガロウイルス感染症と確定診断した新生児 23人を対象とし、血中総igm、サイトメガロ ウイルスigm、サイトメガロウイルス抗原陽 および2 型、水痘帯状疱疹ウイルス(vzv)、サイト メガロウイルス(cmv)などの端~上行結腸近位部) 9.両側肺ブラ 10.サイトメ ガロウイルス肝炎治療後(臨床)(重量:1030 g) 11. 子宮平滑筋腫 12.副腎萎縮(重量:両側とも3 g) 指定発言 今回の症例である皮膚筋炎(dermatomyositis, DM)概要 サイトメガロ ウイルス (CMV)とは、どこにでも存在するありふれたウイルスです。 唾液、尿、血液などの体液を介して感染します。 正常な免疫機能を持っている人がサイトメガロウイルスに感染すると、ときに 肝炎 などを生じることもありますが、風邪をひいた程度の症状でおさまってしまうことが多いです。 妊婦になってからサイトメガロウイルスに



サイトメガロウイルス感染症 精神科医めがね先生の子育てブログ



12 2 感染症 一般社団法人日本造血 免疫細胞療法学会
意が必要である.今回我々はGPSの治療中に,サイト メガロウイルス(cytomegalovirus;CMV)肺炎を合併 し抗ウイルス薬投与にて救命しえた1例を経験したので 報告する. 症例 63歳,男性. 主訴:血尿,血痰. 既往歴:特記事項なし. 家族歴:特記事項なし.も同性愛者で,カポジ肉腫のほかにもカリニ肺炎やサイト メガロウイルス感染症などを合併している例が多く,免疫 不全症を発症していることは明らかだった.ここからエイ ズの発見につながったことは周知の事実であり,以来,カ5肺・胸膜 (8)ウイルス性肺炎(巨細胞封入体(CMV)肺炎)病理コア画像 5肺・胸膜 ★ (8)ウイルス性肺炎(巨細胞封入体(CMV)肺炎) ミクロ像(パパニコロウ染色強拡大): BAL(気管支肺胞洗浄)液の細胞診でも発見される。 フクロウの目(owl's eye)と称される核は特徴的である。 画像をクリックすると拡大表示します。



野村俊一 Atl 免疫能低下 日和見感染症 細菌感染症 ニューモシスチス肺炎 クリプトコッカス肺炎 髄膜炎 全身の カンジダ症 アスペルギルス症 真菌感染症 サイトメガロウイルス肺炎 網膜炎 消化管感染症 汎発性帯状疱疹 ウイルス感染症 糞線

Ct画像あり ウイルス性肺炎まとめ 種類から症状 診断 治療まで
感染症 (→サイトメガロウイルス感染症) 疫学 小児期にほとんど感染 → 近年成人の罹患率が低下しつつある。 感染経路 垂直感染:母子感染(経胎盤。経産道。経母乳) 水平感染:唾液、尿、精液、子宮頸管分泌液。本記事で取り上げるサイトメガロウイルスは、 TORCH症候群 の中でも高い頻度で胎児感染を起こし、更には乳幼児に神経の障害を来す可能性があるウイルスです。 「サイトメガロウイルス」という名前は、ギリシャ語の"cyte"(細胞)と"megalo"(メガロ)に由来しており、文字通り感染細胞が巨大化して周囲の細胞に広がっていくという特徴を持っています肺:多発性から癒合性、重度、慢性、多核巨細胞及び核内サイト メガロウイルス封入体を伴う好中球性組織球性間質性肺炎 JPCの診断 1 Lung Pneumonia, interstitial, histiocytic, with numerous viral syncytial giant cells 2 Lung, alveolar macrophages



ニューモシスチスとサイトメガロウイルス肺炎による重症呼吸不全に対しecmoを用いて救命したhiv患者の1症例 Severe Respiratory Failure With Pneumocystis Jirovecii And Cytomegalovirus Pneumonia In An Hiv Positive Patient Treated Successfully By Extracorporeal



ウイルス性肺炎 かまなか内科 呼吸器内科クリニック
· POINT サイトメガロウイルス肺炎とは サイトメガロウイルスが肺に感染を起こした病気です。 通常の免疫を持った健常者でこの病気になる人は少なく、多くは免疫力の低下した人に起こります。 特にエイズや移植行った人は注意が必要です。 主な症状は、発熱・息切れ・咳・呼吸困難感などです。 身体所見・画像検査・遺伝子検査・血液検査などを総合して診断しトメガロウイルス感染症(1999 気管支肺胞洗浄液を用いたシェルバイアル法でcmvが検出された場合,cmv肺炎 れの方法も,末梢血より分離した多形核白血球を,スライド1枚に対して,15万個サイトサイトメガロウイルスの感染経路 サイトメガロウイルスの感染力は高く、唾液による飛沫感染が主な感染経路。 感染後も体内に居続けるウイルスですが、他の人に感染させるリスクがあるのは、感染後、年の単位に及びます。 飛沫感染だけでなく、性交渉や、輸血によっても感染します。 「幼児→母→胎児」という経路で感染することもあります。 母体に



サイトメガロウイルス感染症 臨床外科 74巻11号 医書 Jp



サイトメガロウイルス Wikipedia
サイトメガロウイルス(CMV)腸炎 CMVはヘルペス科のDNAウイルスでヒト以外には感染しませんのでヒトが唯一の感染源です。 熱に弱く細胞外では不安定でヒトからヒトヘの伝播では濃厚な接触が必要です。 わが国では小児期までの不顕性感染が多く、終生持続感染します。 思春期以降に初感染した場合は 伝染性単核球症 を発症します。 発熱、肝機能異常、肝脾腫・ 心臓または腎臓-膵臓移植患者のサイト メガロウイルス感染予防; -900mg(450mg錠を2錠)を1日1回 移植後10日以内から100日まで投与. ・ 腎臓移植患者のサイトメガロウイルス感 染予防; -900mg(450mg錠を2錠)を1日1回イトメガロウイルス感染症の診療ガイドライン 11"を刊行するにあたり, 一言ご挨拶を申し上げます. 本ガイドラインは,東邦大学医学部腎臓学教室 相川 厚教授を委員長とし て執筆者一覧にのせました4名の先生方を委員に選出し,作成を依頼しました.



衛生学 ゴロで覚える日和見感染症 森元塾 国家試験対策 Note


間質性肺疾患シリーズ やさしイイ呼吸器教室
早期診断、早期治療がなされない場合は、発熱、間質性肺炎、腸炎、肝 炎、網膜炎、脳炎を発症し、移植臓器を失うことにもつ Landing Page Home (current) Catalog Forum Best サイト メガロ ウイルヒトサイトメガロウイルス(以下CMV)感染症は、CMVの初感染、再感染あるいは再活性化によって起こる病態で、感染と感染症は異なることを明 確にする必要がある。 通常、幼小児期に不顕性感染の形で感染し、生涯その宿主に潜伏感染し、免疫抑制状態下で再活性化し、種々の病態を引き起こす。 このウ イルスが感染症を発症するのは主に胎児(一部は先天性CMV



3 サイトメガロウイルス感染症 サイトメガロウイルス肺炎を中心に 化学療法の領域 29巻9号 医書 Jp



びまん性小粒状影の鑑別 永寿総合病院呼吸器ブログ



Pms担当者研修テキスト 12 Pmsフォーラム作成 重篤副作用疾患シリーズ 13 間質性肺炎 重篤副作用疾患 シリーズ 13 Ppt Download



ニューモシスチス肺炎 カリニ肺炎 Pcp のct画像診断のポイント



Ct画像あり ウイルス性肺炎まとめ 種類から症状 診断 治療まで



信州大学医学部附属病院 呼吸器 感染症 アレルギー内科 牛木淳人 Ppt Download



剛龍 على تويتر 難病iga腎症 現在毎日1 経口ステロイド6場の療法中 副作用が辛い 脱毛 感染症ニューモシスチス肺炎 サイトメガロウイルス 真菌 カビ 脂質代謝異常 筋力低下 諸々 抗がん剤の副作用より全然軽いが 他の薬等も有害になるから風邪やインフルエンザ



特発性間質性肺炎 間質性肺炎 シスメックスプライマリケア


間質性肺疾患シリーズ やさしイイ呼吸器教室



間質性肺炎 Ip 呼吸器の病気 はるひ呼吸器病院 愛知県清須市の呼吸器内科 呼吸器外科



ニューモシスチス肺炎 カリニ肺炎 Pcp のct画像診断のポイント



エイズ 看護師の用語辞典 看護roo カンゴルー


腎臓移植について 東京女子医科大学 腎臓外科



サイトメガロウイルス肺炎 臨床検査 35巻7号 医書 Jp



日和見感染症 侵襲性肺アスペルギルス症 ニューモシスチス肺炎 サイトメガロウイルス肺炎 粟粒結核 Medicina 53巻8号 医書 Jp



投稿 症例報告 両肺びまん性に多発囊胞性陰影を呈したhiv感染症に合併したニューモシスチス肺炎の1例 寺島俊和 ほか



症例解説 呼吸器感染症の分類と画像パターン アンターメディア


肺炎 Wikipedia



免疫抑制状態のときに注意するべき呼吸器感染症 サイトメガロウイルス肺炎 臨床雑誌内科 104巻5号 医書 Jp


気管支肺胞洗浄 Bal 法の手引き 克誠堂出版


ノニは新型コロナウイルス肺炎に有効か 中鎖脂肪酸の観点より M Kラボラトリーズ



T細胞の老化と免疫老化 ライフサイエンス 領域統合レビュー



肺炎 肺化膿症とは コトバンク



サイトメガロウイルス肺炎 Medicina 23巻7号 医書 Jp



Ppt 後天性免疫不全症候群 Powerpoint Presentation Free Download Id



ペストとは



症例解説 サイトメガロウイルス感染症 アンターメディア



12 感染症 4 サイトメガロウイルス Cmv 臨床検査 51巻12号 医書 Jp



投稿 症例報告 両肺びまん性に多発囊胞性陰影を呈したhiv感染症に合併したニューモシスチス肺炎の1例 寺島俊和 ほか



べんぜん 薬学生インフルエンサー サイトメガロウイルス肺炎の治療薬 のゴロ 全てのゴロが見たい方はinstagram T Co Gsxryk7fvw


上肺野 上葉 優位の画像所見を呈するニューモシスティス肺炎症例 さいたま赤十字病院呼吸器内科 こちら彩の国 呼吸器科



2 ステロイド 免疫抑制剤併用による間質性肺炎治療中 間質性肺炎の悪化と血中サイトメガロ ウイルスアンチゲネミア B Dグルカンの上昇を認めた48歳の女性 サイトメガロウイルス肺炎とニューモシスティス肺炎の合併 検査と技術 40巻10号 医書 Jp



Review 免疫不全患者の重症呼吸器感染症 リウマチ膠原病徒然日記



Aids 後天性免疫不全症候群 とは



商品詳細ページ メディカルブックセンター



消化管感染症の病理 サイトメガロウィルス性食道炎 感染症の病理学的考え方



すりガラスの不透明度とは何ですか 3dicomビューア



感染症領域 挑む グラム染色ー感染症診療におけるグラム染色の再考 Medical Education 医薬品 適正使用情報 Msd Connect


間質性肺疾患診療マニュアル 改訂第3版 久保 惠嗣 監修 南江堂 版元ドットコム



院内肺炎 ニューモシスチス肺炎 サイトメガロウイルス肺炎を中心に Medicina 51巻10号 医書 Jp


間質性肺疾患シリーズ やさしイイ呼吸器教室



投稿 症例報告 両肺びまん性に多発囊胞性陰影を呈したhiv感染症に合併したニューモシスチス肺炎の1例 寺島俊和 ほか



0 件のコメント:
コメントを投稿